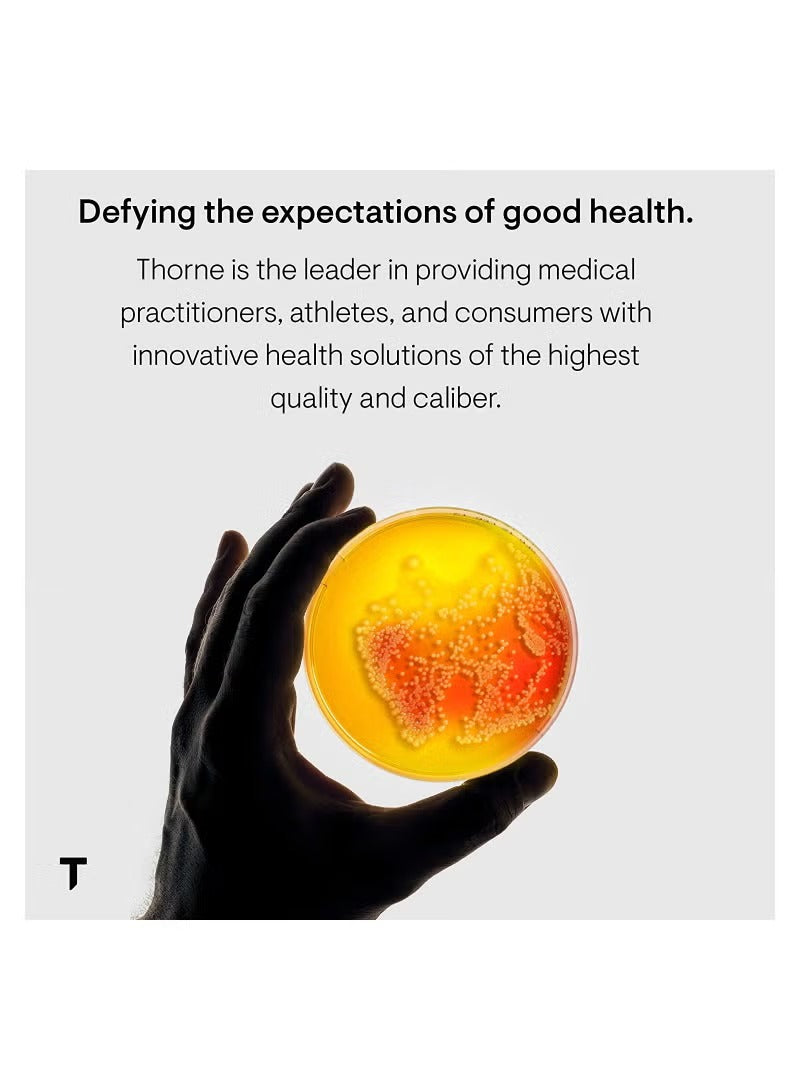
Thorne Magnesium CitraMate capsules UAE for optimal health and wellness support

سيترامات المغنيسيوم - 90 كبسولة
✅ Adding this product qualifies you for Free Shipping!
🚀 Delivery Time: Fastest Delivery 2 Days
سياسة الشحن والإرجاع
مكمل سيترامات المغنيسيوم الفاخر من ثورن لدعم إنتاج الطاقة، ووظائف القلب والرئة، وصحة العظام، ووظائف العضلات والكلى. خالٍ من مسببات الحساسية الشائعة، ومصنوع من مكونات عالية الجودة لامتصاص مثالي.
أبرز الميزات:
-
صحة مثالية: يدعم إنتاج الطاقة، ووظائف القلب والرئة، وصحة العظام، واستقلاب السكريات والكربوهيدرات
-
دعم العضلات: يساعد المغنيسيوم والمالات على تخفيف آلام العضلات العرضية
-
صحة الكلى: يساعد سترات المغنيسيوم على تقليل مستويات أكسالات الكالسيوم والفوسفات في البول
-
خالي من مسببات الحساسية: الجلوتين، ومنتجات الألبان، والبيض، وفول الصويا، والأسماك، والمحار، والمكسرات، والفول السوداني، والخميرة
-
علامة تجارية موثوقة: تحظى شركة Thorne بثقة الرياضيين المحترفين والفرق الأولمبية، كما تتعاون مع Mayo Clinic في أبحاث العافية
-
تصنيع عالي الجودة: يلتزم بممارسات التصنيع الجيدة (cGMPs) الخاصة بإدارة الغذاء والدواء الأمريكية، وحاصل على شهادة NSF للرياضة، ولا يحتوي على مواد مالئة أو طلاءات أو ستيرات المغنيسيوم غير الضرورية
تحديد:
-
وزن المنتج: 176.9 جرام
-
القسم: للجنسين
-
أبعاد المنتج: 4.23 × 4.23 × 2.38 بوصة
-
مدة الصلاحية: 900 يوم
-
الكمية: 90 كبسولة
-
اسم الموديل: ثورن ريسيرش - سيترامات المغنيسيوم
-
رقم الموديل: M272-R
المنتجات ذات الصلة

أحدث المشاركات
عرض الكلالبربرين لإنقاص الوزن: كيف يمكن لهذا المركب الطبيعي أن يساعد في تغيير عملية التمثيل الغذائي لديك
كيفية حماية نفسك من عمليات الاحتيال في التجارة الإلكترونية: التسوق الآمن عبر الإنترنت أصبح بسيطًا
أفضل عروض التسوق في دبي: خصومات وعروض ترويجية لا تُضاهى هذا الأسبوع
أفكار مميزة لتزيين المنزل: طرق إبداعية لتجديد مساحتك
كيفية التسوق الذكي في دبي: نصائح للمتسوقين المهتمين بالميزانية
🌟 عالم لابوبو الغريب: لماذا تسيطر هذه الألعاب المشاغبة على رفوف هواة الجمع؟
- يؤدي اختيار التحديد إلى تحديث الصفحة بالكامل.
























































